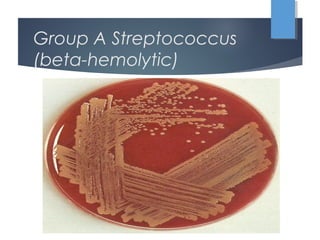
Group A Streptococcus
(beta-hemolytic)

This document discusses various infectious causes of pharyngitis (sore throat), including viruses like Epstein-Barr virus, measles, and fungal infections like candidiasis. It focuses in detail on group A streptococcus bacteria as a common cause of strep throat and notes physical exam findings and complications. Diphtheria caused by Corynebacterium diphtheriae is also discussed.